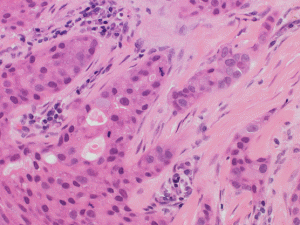
W{gDffGZ

病理診断科では、病理診断を行う医師(病理医)が、病理標本を観察して診断を行います。
病理標本とは、患者さんの身体から手術や検査などで採取された組織や細胞であり、そこに隠れている病気を顕微鏡で詳細に観察し、病理診断を下します。顕微鏡下に広がる組織や細胞像から病気であることを同定するためには、病理学の知識が必要です。病理学とは、病気の理屈を考える学問で、なぜ病気になるのか? 病気にかかった人はどのような症状を出し、その後どうなっていくのか?などを読み解く学問です。
病理診断は、検査する標本(組織や細胞)により組織診断と細胞診断に分けられます。
大きな病気の一部を採ってきて、その病気の性格を知り、病理診断します。
たとえば、胃カメラをやって、大きな腫瘍があったとします。はじめてやった胃カメラで大きな腫瘍全部を取り出すことはできません。それが、胃癌なのか?良性腫瘍なのかで今後の手術方法も変わります。そのため、腫瘍のごく一部(米粒ほどの大きさ)を採取して病理検査するのが組織診断です。
b)手術標本の組織診断
生検診断で手術した方がよいと診断されると、いよいよ手術になります。外科医によって身体から取り出された手術標本(摘出標本)は、さらに詳しく検査するために病理検査に供されます。その目的は、腫瘍などの病変が全て取りきれているか? リンパ節などへ転移していないか? など、腫瘍の再発などを予想して、今後の治療方針に役立つ情報を得るためです。
たとえば、胃癌で胃袋の一部だけを摘出し、あとの胃袋を残す手術方法があります。胃袋という消化に重要な臓器を少しでも身体に残しておくことは手術後の食生活にとても大切なことです。しかし、そこに胃癌が残っていては困ります。胃癌を完全に取りきれていることがとても大切なことであり、摘出標本を詳しく検査することでこれを予想することができます。
さらに、最近では分子標的治療という新しい抗癌治療が一般的になってきました。これは今まで有効な治療方法がなかったような癌にも非常に高い効果を発揮し、癌を消滅させることもできるようになりました。この画期的な治療方法が患者さんに適しているか否かを判定するのも病理医の仕事です。
生検標本組織診断;浸潤性乳癌

分子標的治療;HER-2(茶色に染色された細胞)
c)術中迅速診断
手術中にも病理医は外科医と連携しています。手術の現場で、腫瘍が取りきれているかどうかはとても大切です。腫瘍の切除範囲を決めるときに、手術中に切取られた切除断端部分に癌細胞が残っていないかを見きわめるために、切除断端の組織を顕微鏡で検査することがあります。これが術中迅速診断です。切除範囲を最小限にとどめるための大切な情報を提供しています。
肺癌や膀胱癌では、痰や尿の中に癌細胞が出てくることがあります。これらの検体の中に癌細胞がいるのを見つけられれば、痛みや苦痛もなく癌の診断ができます。また、子宮癌は子宮の入り口や内部から小さなブラシで擦り取った細胞で診断でき、乳癌はしこりから細い針で採取された細胞を顕微鏡で見ることで癌の有無を診断できます。これが細胞診断です。
病理医がいる病院のメリット
病理医は、臨床医から提出された病変部の標本から病気の性格を見ることができます。同じ臓器の病気と言えども、形や性格は多種多様です。たとえば腫瘍であれば悪性か良性かだけでなく、増大する早さや転移、再発する危険性などを知ることができます。そのような病気の性格が患者さんの症状や将来の生活を大きく変えてしまうことがあります。病院内に病理医がいることで、臨床医と直接面談しながら病気の情報を交換し緊密な医療連携をとることができ、診療の質を向上することができます。